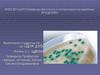
Бруцеллёз (лат. brucellosis)

Similar presentations:
Бруцеллёз. Лептоспироз
1.
Учреждение образования«Пинский государственный медицинский колледж»
Дисциплина: «Сестринское дело при инфекционных заболеваниях»
Специальность: «Сестринское дело» 2 курс
Теоретическое занятие 18.
Тема: «Бруцеллёз. Лептоспироз»
2.
Вопросы занятия № 17:1. ВИЧ-инфекция
Вопросы на занятии 18:
1. Бруцеллёз (МКБ-10: А27)
2. Лептоспироз (МКБ-10: А23)
3.
БРУЦЕЛЛЁЗ (Б.) – зоонозноеинфекционно-аллергическое
заболевание,
характеризующееся
длительной лихорадкой,
поражением опорнодвигательного аппарата,
нервной, урогенитальной и
других систем организма.
ЛЕПТОСПИРОЗ (Л.) – острое
зоонозное заболевание,
характеризующееся
лихорадкой, интоксикацией,
поражением почек, печени,
нервной и сосудистой систем,
мышц с развитием
геморрагического синдрома
и нередко желтухи
Бруцеллез, вызванный Br. мelitensis (A23.0).
Бруцеллез, вызванный Br. аbortus (А23.1).
Бруцеллез, вызванный Br. suis (А23.2).
Бруцеллез, вызванный Br. canis (А23.3).
Другие формы бруцеллеза (А23.8)
Лептоспироз (A27).
Лептоспироз желтушно-геморрагический (A27.0).
Другие формы лептоспироза (A27.8).
Лептоспироз неуточненный (A27.9)
4.
ЭТИОЛОГИЯ Б.БРУЦЕЛЛЫ – это мелкие
грамотрицательные
неподвижные микробы,
содержащие эндотоксин.
ВИДЫ БРУЦЕЛЛ:
Brucella melitensis, вызывающая заболевание
мелкого рогатого скота (овец, коз);
b.abortus bovis, вызывающая бруцеллез крупного
рогатого скота;
b.abortus suis, поражающая преимущественно
свиней, и
b.canis – возбудитель бруцеллеза собак.
ВОЗБУДИТЕЛЬ Б.:
устойчив во внешней среде,
длительно сохраняет жизнеспособность при
низких температурах,
мгновенно погибает при кипячении,
дезинфектанты в рабочих концентрациях губят в
течение нескольких минут.
ЭТИОЛОГИЯ Л.
ЛЕПТОСПИРЫ подвижны,
грамотрицательны, относятся
к роду лептоспир (Leptospira),
имеет спиралевидную форму.
СЕРОГРУППЫ:
L. icterohaemorrhagica,
L. grippotyphosa,
L. pomona,
L. canicola,
L. tarasovi.
ВОЗБУДИТЕЛЬ Л.:
хорошо растут на средах, содержащих сыворотку крови,
будучи гидрофилами, они хорошо сохраняются во влажной
среде: в воде озер, рек, болот - в течение нескольких недель,
а в почве – до нескольких месяцев
устойчивы к низким температурам (даже к замораживанию),
но моментально погибают при кипячении,
чувствительны к воздействию прямых солнечных лучей,
высушиванию,
дезинфицирующим средствам.
5.
ЭПИДЕМИОЛОГИЯ Б.:ЭПИДЕМИОЛОГИЯ Л.
ИСТОЧНИК ИНФЕКЦИИ:
сельскохозяйственные животные: овцы, козы, крупный
рогатый скот, свиньи.
ИСТОЧНИК ИНФЕКЦИИ:
промысловые животные (лисы, песцы, нутрии) и
сельскохозяйственные животные (свиньи и крупный
рогатый скот, лошади, овцы, козы),
грызуны - лесные мыши, полевки, водяные крысы и т.п.
Заболевание бруцеллезом животных в период
беременности в большинстве случаев влечет за собой
аборт. У больных животных бруцеллы выделяются с мочой,
испражнениями и молоком, а у абортировавших - и с
околоплодной жидкостью.
МЕХАНИЗМ ЗАРАЖЕНИЯ: фекально-оральный,
ПУТЬ – алиментарный
ФАКТОР ЗАРАЖЕНИЯ: чаще всего являются
инфицированные мясо и сырые молочные продукты
(молоко, сыр, брынза).
МЕХАНИЗМ ЗАРАЖЕНИЯ: контактный, ПУТЬ – прямой.
ФАКТОР ЗАРАЖЕНИЯ: через кожные покровы людей при
обслуживании животных или обработке их сырья, особенно
при оказании помощи при отеле, окоте, опоросе.
Животные с мочой выделяют лептоспир во внешнюю среду.
МЕХАНИЗМ ЗАРАЖЕНИЯ: фекально-оральный,
ПУТЬ – алиментарный, водный
ФАКТОР ЗАРАЖЕНИЯ: при купании и использовании воды
из открытых водоемов, употреблении инфицированных
пищевых продуктов
МЕХАНИЗМ ЗАРАЖЕНИЯ: контактный,
ПУТЬ – прямой, непрямой
ФАКТОР ЗАРАЖЕНИЯ: через поврежденные кожные
покровы (при наличии микротравм) или неповрежденные
слизистые оболочки полости рта, носа, глаз.
Больной человек не является источником инфекции.
Рост заболеваемости отмечается в летне-осенний период.
Постинфекционный иммунитет стойкий и типоспецифичный и не
защищает от заражения другими сероварами лептоспир.
6.
ПАТОГЕНЕЗ Б.:ПАТОГЕНЕЗ Л.:
1. Возбудитель проникает в организм человека через кожу
(особенно при наличии микротравм) или слизистые
оболочки
2. Возбудитель захватывается макрофагами
3. Возбудитель размножается в макрофагах
4. Возбудитель с током лимфы заносится в регионарные
лимфатические узлы
5. Возбудитель попадает в кровь
6. Возбудитель по кровеносным сосудам распространяется
в органы и ткани (печень, селезенка, костный мозг)
7. При повторной многократной диссеминации
возбудителя из метастатических очагов развиваются
реактивно-аллергические изменения
8. Хронизация процесса
1. Входными воротами инфекции являются кожа при
наличии микротравм, слизистые оболочки ротовой
полости, носа, глаз, желудочно-кишечного тракта
2. На месте внедрения возбудителя первичного аффекта
не возникает
3. Возбудитель преодолевает лимфатический барьер
4. Возбудитель попадает в кровь
5. Возбудитель заносится в различные органы и ткани
(печень, селезенку, почки, легкие, ЦНС)
6. Происходит размножение возбудителя
7. Развитие в органах дегенеративно-воспалительных
процессов
8. Развитие острой почечной и печеночной
недостаточности, геморрагического синдрома,
менингита
7.
КЛИНИКА Б.КЛИНИКА Л.
Инкубационный период – от 6 до 30 дней. Заболевание развивается постепенно. 4
Инкубационный период – от 4 до 14 дней.
основные жалобы:
Есть две формы болезни — желтушная и
перемещающаяся боль в суставах, преимущественно в нижних конечностях,
иногда весьма сильная и мучительная.
безжелтушная.
повышение температуры тела в виде длительного субфебрилитета (до 38°C)
Желтушная форма — инкубационный период
или волнообразного типа с резкими подъёмами и падениями.
1—2 недели. Начало острое, температура до
усиленная потливость, испарина, иногда ночная потливость.
40, общая слабость, склеры инъецированы.
резкая слабость и упадок сил.
Со 2—3 дня увеличивается печень, иногда
Системные поражения многообразны и затрагивают практически все органы.
селезёнка, появляется иктеричность склер,
Встречаются:
Опорно-двигательный аппарат – септический моноартрит, асимметричный кожи и появляются интенсивные мышечные
боли (в икроножных мышцах). С 4—5 дня
полиартрит коленного, тазобедренного, плечевого сакроилиального и
грудиноключичного соединений, остеомиелит позвоночника, миалгия.
возникает олигурия, затем анурия. Со
Сердце – эндокардит, миокардит, перикардит, абсцесс корня аорты,
стороны сердечно-сосудистой системы
тромбофлебит, причём эндокардит может развиться и на неизменённых ранее
тахикардия, может быть инфекционный
клапанах.
миокардит. Также есть геморрагический
Дыхательная система – бронхит и пневмония.
синдром (чаще во внутренние органы) — и,
Пищеварительная система – безжелтушный гепатит, анорексия и потеря веса.
следовательно, анемия.
Мочеполовая система – эпидидимит, орхит, простатит, тубоовариальный
абсцесс, сальпингит, цервицит, острый пиелонефрит.
Безжелтушная форма — инкубационный
Центральная нервная система – менингит, энцефалит, менингоэнцефалит,
миелит, церебральные абсцессы, синдром Гийена-Барре, атрофия зрительного
период 4—10 дней. Поднимается
нерва, поражение III, IV и VI пар.
температура, слабость, появляются
Лимфатические узлы – лимфаденит
менингеальные симптомы, олигоанурия, ДВС Селезёнка – увеличение селезёнки
синдром, увеличение печени.
Глаза – кератит, язвы роговицы, увеит, эндофтальмит.
8.
ОБЯЗАТЕЛЬНАЯ СТАЦИОНАРНАЯ ДИАГНОСТИКА Б.:Общий (клинический) анализ крови развернутый.
Общий анализ мочи.
Бактериологическое исследование крови, спинномозговой
жидкости (только при развитии менингита), мочи на бруцеллы
(Brucella spp.)
Определение антител к бруцеллам (Brucella spp.) в крови.
Биохимическое исследование крови: определение уровня
креатинина, мочевины, билирубина, АЛТ, АСТ, СРБ.
ЭКГ.
Клиническое и биохимическое исследование спинномозговой
жидкости (при развитии менингита).
Консультация врача- ревматолога, врача-невролога
ДОПОЛНИТЕЛЬНАЯ СТАЦИОНАРНАЯ ДИАГНОСТИКА Б.:
Бактериологическое исследование крови на стерильность.
Бактериологическое исследование синовиальной жидкости (при
развитии артрита), на бруцеллы (Brucella spp.)
Молекулярно-биологическое исследование крови, спинномозговой,
синовиальной жидкости на ДНК возбудителя.
Рентгенография (обзорная) грудной полости.
Рентгенография суставов (в зависимости от локализации
поражения).
Консультация врача-хирурга, врача-уролога, врача акушерагинеколога, врача-фтизиатра, врача-кардиохирурга
ОБЯЗАТЕЛЬНАЯ СТАЦИОНАРНАЯ ДИАГНОСТИКА Л.:
Общий (клинический) анализ крови развернутый.
Общий анализ мочи.
Биохимическое исследование крови: определение
уровня креатинина, мочевины, билирубина,
креатинкиназы, АЛТ, АСТ, электролитов (К, Na, Cl).
Исследование показателей гемостаза.
Определение антител к лептоспире (Leptospira spp.) в
крови.
Клиническое и биохимическое исследование
спинномозговой жидкости (при развитии
менингита).
УЗИ органов брюшной полости, почек (комплексное).
Рентгенография (обзорная) грудной полости
ДОПОЛНИТЕЛЬНАЯ СТАЦИОНАРНАЯ ДИАГНОСТИКА Л.:
ЭКГ.
Молекулярно-биологическое исследование крови на
ДНК возбудителя.
Консультация врача-нефролога, врача-невролога
9.
ЛЕЧЕНИЕ Б.:ЛЕЧЕНИЕ Л.:
1. Лечебное питание (диета М).
2. Антибактериальная терапия.
2.1. ЛС выбора:
доксициклин 100 мг вутрь 2 раза/сут 6 недель в сочетании с гентамицином 5мг/кг в/в 1 раз/сут 7
дней;
доксициклин 100 мг вутрь 2 раза/сут 6 недель в сочетании с рифампицином 600-900 мг внутрь 1
раз/сут 6 недель.
2.2. При наличии артритов:
(доксициклин 100 мг вутрь 2 раза/сут 6 недель в сочетании с рифампицином 600-900 мг внутрь 1
раз/сут 3 месяца) в сочетании с гентамицином 5мг/кг в/в 1 раз/сут 7 дней;
ципрофлоксацин 750 мг внутрь 2 раза/сут в с с рифампицином 600-900 мг внутрь 1 раз/сут 3
месяца.
2.3. Во время беременности:
сульфаметоксазол/триметоприм 800/160 мг 5 мг/кг (по триметоприму) внутрь 2 раза/сут в
сочетании
рифампицином 600-900 мг внутрь 1 раз/сут 4 недели.
2.4. При поражении нервной системы:
(доксициклин 100 мг вутрь или в/в 2 раза/сут в сочетании с рифампицином 600-900 мг внутрь 1
раз/сут) в сочетании сцефтриаксоном 2000 мг в/в 2 раз/сут до нормализации показателей
спинномозговой жидкости.
3. НПВС:
кеторолак 40-120 мг/сут внутрь или в/м;
метамизол 500-2000 мг/сут внутрь или в/м;
парацетамол 500-2000 мг/сут внутрь.
4. Посиндромное лечение:
синдрома интоксикации,
коррекция нарушений гемостаза,
электролитных нарушений
1. Лечебное питание (диета
М).
2. Антибактериальная терапия:
2.1. ЛС выбора:
бензилпенициллин 1,5-2
млн ЕД в/в 4 раза/сут 7
дней (при менингите – до
24 млн. ЕД/сут), или
цефтриаксон 2 г в/в 1
раз/сут 7 дней.
2.2. Альтернативные ЛС:
доксициклин 100 мг в/в 2
раза/сут 7 дней.
3. Посиндромное лечение:
коррекция нарушений
гемостаза,
электролитных нарушений,
синдрома интоксикации,
септического шока,
острой печеночной
и (или) почечной
недостаточности
10.
ПРОФИЛАКТИКА Б.:Для предупреждения бруцеллеза среди людей требуется ликвидация
заболеваний сельскохозяйственных животных.
Необходимо постоянно проводить ветеринарно-санитарный контроль за
сельскохозяйственными животными в неблагополучных по бруцеллезу регионах.
С целью воздействия на механизм передачи инфекции необходимо проводить
обеззараживание молока и молочных продуктов кипячением и пастеризацией,
термическую обработку мяса, мясопродуктов, обеззараживание шкур и шерсти
животных, постоянно соблюдать правила личной гигиены при контакте с сырьем
животного происхождения.
Специфическая профилактика проводится по эпидпоказаниям живой
противобруцеллезной вакциной с 18-летнего возраста.
ПРОФИЛАКТИКА Л.:
Предупреждение лептоспироза у людей предусматривает проведение комплекса
гигиенических и ветеринарных мероприятий.
В животноводческих и звероводческих хозяйствах выявляются и лечатся больные
животные и лептоспироносители.
Строго соблюдаются санитарно-гигиенические правила, меры личной безопасности
(использование спецодежды при уходе за животными, работе на мясокомбинатах).
Проводятся мероприятия, исключающие доступ грызунов к пищевым продуктам, борьба
с крысами.
Запрещается купание в водоемах, расположенных в эндемичной по лептоспирозу
местности, и употребление воды из открытых водоемов.
В неблагополучных по лептоспирозу регионах взрослым и детям (с 7 лет) проводится
вакцинация убитой лептоспирозной вакциной.
ПРИЛОЖЕНИЕ 2 К ПОСТАНОВЛЕНИЮ МЗ РБ 17.05.2018 № 42
ПЕРЕЧЕНЬ ПРОФИЛАКТИЧЕСКИХ ПРИВИВОК ПО ЭПИДЕМИЧЕСКИМ ПОКАЗАНИЯМ.
ГРУППЫ ФИЗИЧЕСКИХ ЛИЦ, ПОДЛЕЖАЩИХ ПРОФИЛАКТИЧЕСКИМ ПРИВИВКАМ:
Работники животноводческих комплексов (ферм) – до полной ликвидации в
Лица, выполняющие работы по заготовке,
хозяйствах животных, зараженных бруцеллезом козье-овечьего вида
хранению, переработке сырья и продуктов
Работники организаций по заготовке, хранению, переработке сырья и продуктов
животноводства и птицеводства, полученных
животноводства – до полной ликвидации животных, зараженных бруцеллезом
из неблагополучных по лептоспирозу
козье-овечьего типа, в хозяйствах, из которых поступит скот, сырье и продукты
хозяйств либо хозяйств, расположенных на
животноводства
энзоотичных по лептоспирозу территориях;
Работники бактериологических лабораторий, работающие с живыми культурами
убою скота, больного лептоспирозом,
бруцелл, а также с материалом, инфицированным возбудителем бруцеллеза
заготовке и переработке мяса и
Работники организаций по убою скота, больного бруцеллезом козьеовечьего типа,
мясопродуктов, полученных от больных
заготовке и переработке полученных от него животноводческих продуктов
лептоспирозом животных
Животноводы, зооветработники в хозяйствах, энзоотичных по бруцеллезу козье Лица, работающие с живыми культурами
овечьего типа, занятые непосредственным обслуживанием животных
возбудителя лептоспироза
11.
Первое звеноэпидемического процесса
1. Заполнение и отправка экстренного извещения
2. Лечение и изоляция пациента с предположительным диагнозом
3. Обследование лиц, контактирующих с пациентом с предположительным
диагнозом
Второе звено
эпидемического процесса
1. Установка карантина для карантинных заболеваний
2. Прерывание механизма и пути передачи инфекционного заболевания
3. Выполнение правил санитарного противоэпидемического режима в УЗ
Третье звено эпидемического 1.
процесса
2.
3.
Проведение санитарно-просветительной работы среди населения про
инфекции
Применение профилактических прививок по календарю, вакцины, сыворотки
Строгое соблюдение личной гигиены
12.
ОБЩИЙРЕЖИМ
ПОЛУПОСТЕЛЬНЫЙ
РЕЖИМ
ПОСТЕЛЬНЫЙ
РЕЖИМ
СТРОГИЙ
ПОСТЕЛЬНЫЙ
РЕЖИМ
Пациент самостоятельно себя обслуживает, осуществляет мероприятия личной гигиены, свободно ходит по
коридору, в столовую. Ему могут быть разрешены прогулки по территории больницы, в летнем саду
Пациенту разрешается передвигаться в пределах палаты, сидеть на стуле около кровати. Кормление производят в
палате. Мероприятия личной гигиены пациент может осуществлять самостоятельно или с помощью медицинской
сестры
Пациенту разрешается поворачиваться в постели, но не покидать её. Кормление, мероприятия личной гигиены ему
помогает выполнять медицинская сестра
Пациенту не разрешается вставать, садиться, активно двигаться в постели, поворачиваться. Все гигиенические
мероприятия, физиологические отправления он совершает в постели. Медицинская сестра ухаживает за
пациентом, кормит его, осуществляет все мероприятия, необходимые для выполнения правил личной гигиены
тяжелобольного
ОСОБЕННОСТИ НАБЛЮДЕНИЯ И УХОДА ЗА ПАЦИЕНТАМИ:
1. Лечение – выполнение назначений врача
2. Питание
3. Личная гигиена:
3.1. Бельевой режим
3.2. Профилактика пролежней
3.3. Физиологические отправления
3.4. Уход за лицом и телом
13.
Рекомендации к домашнему заданию:Использованные источники информации к занятию:
Основная – «Инфекционные болезни и сестринское дело»
В.И.Комар Минск «Выш. школа», 2013:
с. 352-365, повт. [1], с.299-319
Дополнительная – действующие нормативные правовые акты МЗ
РБ, ГГСВ РБ
подготовить выступление













 medicine
medicine